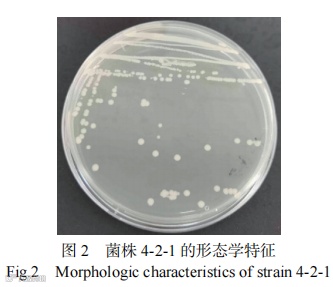

研究背景



内容与结论



展 望


作者简介
方海田
宁夏大学教授,博士生导师
食品科学与工程学院副院长
主要从事特色农产品生物加工与微生物发酵方面的工作。现为宁夏回族自治区青年拔尖人才培养工程(国家级学术技术带头人后备人员),贺兰山学者-特聘学者,宝钢教育优秀教师奖,公派留学新西兰林肯大学访问学者,兼任宁夏食品科学技术学会副理事长、宁夏食品工业协会首席专家等多项社会职务。近5年主持国家自然科学基金项目3项,省部级科研项目12项;发表论文60余篇,编写教材5部,编写英文专著1部;获授权国家发明专利11件、软件著作权11件,登记科技成果4件。技术与产业化成果荣获宁夏科技进步二等奖(排名1)、宁夏科技进步三等奖(排名1),形成了显著的经济社会效益。

详细内容请点击文末“阅读原文”。
食品科学家论文汇总
(点击专家姓名,查看论文)













《食品工业科技》特邀主编专栏征稿
《食品工业科技》青年编委专栏征稿:AI for Food Industry:人工智能在食品工业中的应用 ☚
《食品工业科技》青年编委专栏征稿:组学分析技术在食品品质研究中的应用 ☚
群聊:食品工业科技作者群

温
馨
提
示

我刊正式组建微信作者群,为作者提供更多的学术与论文资讯,如需进群,请联系刘老师(微信:上方二维码,电话:87244117-8062)。